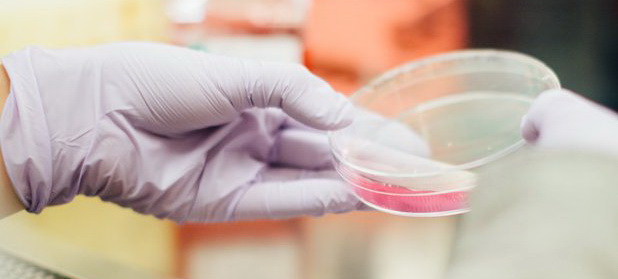

4 focare cu 17 cazuri de rujeola in Maramures

Informam populatia judetului Maramures ca incepand cu luna decembrie 2018 s-au inregistrat 4 focare cu 17 cazuri de rujeola dintre care cele mai multe in municipiul Baia Mare.
Toate cazurile sunt la persoane nevaccinate sau cu antecedente vaccinale necunoscute.
Ca urmare, solicitam medicilor de familie sa mobilizeze de urgenta parintii copiilor eligibili la cabinet in vederea vaccinarii si sa informeze parintii asupra consecintelor nevaccinarii/amanarii vaccinarii din motive neintemeiate.
Medicii din cabinetele unitatilor de invatamant vor efectua zilnic triajul epidemiologic in vederea depistarii cazurilor suspecte si evitarea raspandirii cazurilor in colectivitate.
Datorita gravitatii bolii si raspandirii rapide datorita transmiterii pe ale respiratorie/contagiozitatii ridicate si a perioadei de incubatie scurte, recomandam ca in caz de suspiciune de rujeola, parintii sa cheme la domiciliu medicul de familie pentru consult sau sa apeleze Serviciul de ambulanta in vederea prezentarii la cea mai apropiata sectie de boli infectioase.
D.S.P. Maramures dispune de cantitati suficiente de vaccin rujeolic si la nevoie poate suplimenta dozele la cabinetele medicilor de familie.